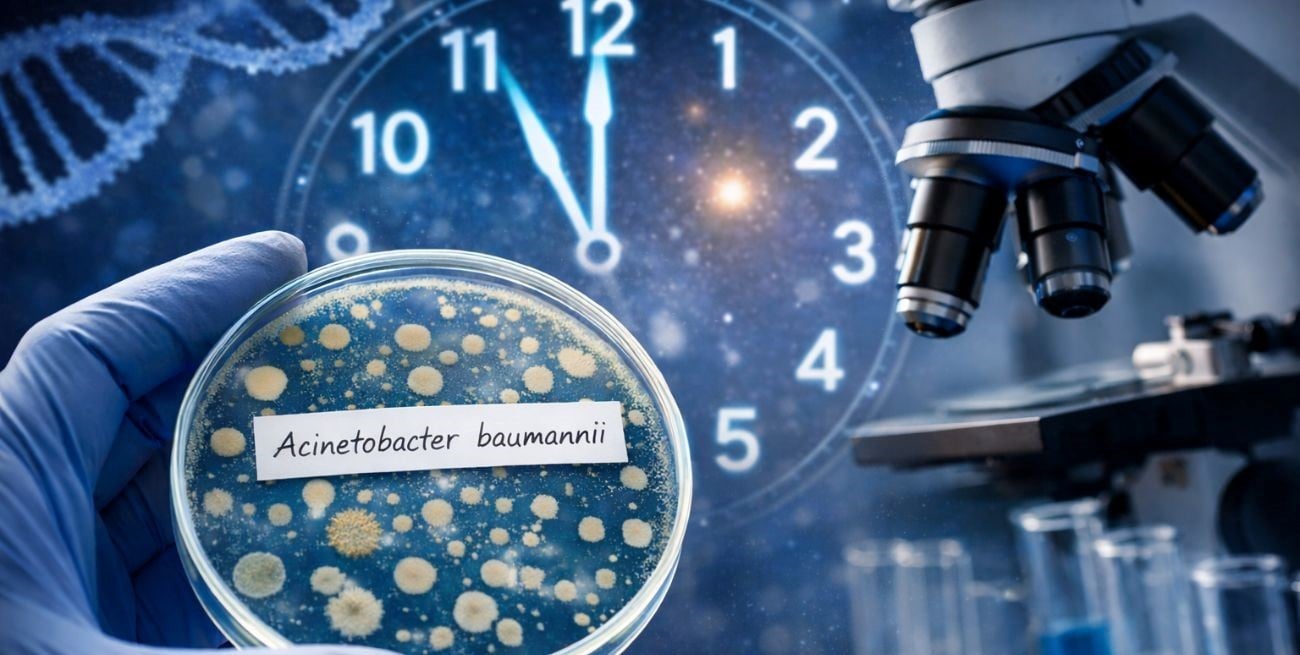
Una bacteria crítica para la salud tiene reloj biológico y abre una nueva mirada sobre las infecciones

Un equipo de investigadores del CONICET confirmó que la Acinetobacter baumannii —una bacteria multirresistente responsable de infecciones intrahospitalarias— posee un reloj biológico interno que responde a los ciclos de luz y oscuridad, un rasgo sorprendente que podría influir en la comprensión de su virulencia y en la forma de enfrentar tratamientos antibióticos. El trabajo fue publicado en la revista Communications Biology.